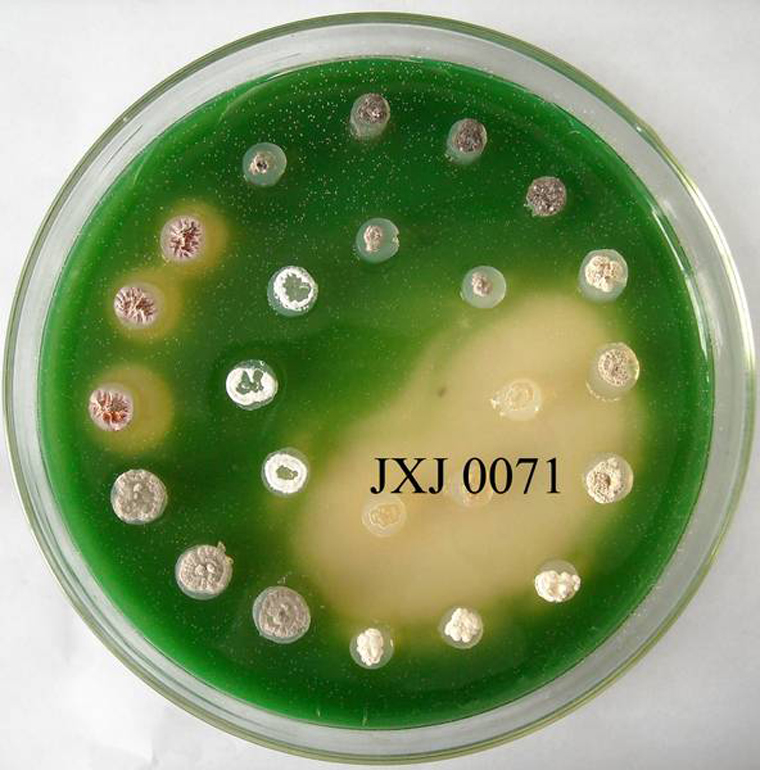
铜绿微囊藻

铜绿微囊藻细胞
铜绿微囊藻
图片尺寸500x378
microcystis aeruginosa铜绿微囊藻
图片尺寸675x443铜绿微囊藻
图片尺寸2048x1536铜绿微囊藻
图片尺寸893x670铜绿微囊藻
图片尺寸1257x560铜绿微囊藻
图片尺寸800x600
铜绿微囊藻
图片尺寸220x165铜绿微囊藻
图片尺寸642x479
浮游植物----中国湿地生态系统联盟
图片尺寸2272x1704
藻种鉴定,这是小球藻还是铜绿微囊藻?_答魔科研
图片尺寸600x452
微囊藻
图片尺寸400x234
铜绿微囊藻小型变种
图片尺寸220x165
油镜下放大400倍的铜绿微囊藻
图片尺寸150x112
显微镜下的绿藻细胞(像竹子一样)
图片尺寸2200x1650
藻种鉴定,这是小球藻还是铜绿微囊藻?_答魔科研
图片尺寸600x452
求大牛帮忙鉴定是否是微囊藻 - 微生物 - 分类/鉴
图片尺寸675x900
棕鞭藻及其培养滤液对铜绿微囊藻生长及生理特性的影响
图片尺寸1575x610
浮游植物----中国湿地生态系统联盟
图片尺寸4080x3072
铜绿假单胞菌性角膜炎怎么治疗
图片尺寸600x375铜绿微囊藻
图片尺寸760x770